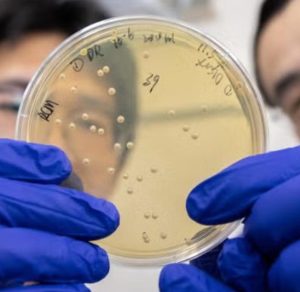

The U.S. Department of Energy’s Advanced Research Projects Agency-Energy (ARPA‑E) has awarded UC Davis researchers a $3 million grant to develop a bio‑based process that selectively captures rare earth elements from acidic mine‑influenced and industrial wastewater streams.
Keep Reading This Article at Electronics Weekly